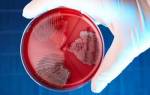

Анализы мочи необходимы, чтобы выявить сопутствующие расстройства, которые могут стать фатальными для больного с мочекаменной болезнью. Они позволяют обнаружить и предупредить опасные для жизни патологии.
Главным исследованием является общий анализ урины. Клинические и биохимические тесты проводят, чтобы определить состав выделяемой мочи. По ним оценивают цвет, мутность, запах и прочие показатели. Кроме того, по полученным результатам определяют содержание солей и их состав, наличие белка и эритроцитов. Присутствие в моче этих компонентов свидетельствует о развитии воспалительного процесса.
Биохимия мочи позволяет определить рН среды, что помогает установить состав конкрементов в почках. Если урина кислая, причиной мочекаменной болезни стали ураты; при щелочной реакции – фосфатные камни, а слабокислая указывает на оксалаты.
Недуг часто сопровождается воспалительным процессом. Для его диагностики, выявления типа болезнетворных микроорганизмов, поразивших почки, проводят бактериологический посев. Он позволяет установить титр микробов, резистентность их к антибактериальным препаратам. Это необходимо, чтобы назначить адекватное лечение.
Часто камнеобразование проходит бессимптомно. Недуг обнаруживают при плановой диспансеризации и жалобах на расстройства работы других органов. Исследование мочи позволяет выявить болезнь на начальной стадии, а также установить причину ее развития. Результаты анализов – повод для дальнейшего обследования и подбора эффективной схемы лечения.
После исследований результаты интерпретирует лечащий врач.
Анализы включают
- оценку органолептических, химических показателей;
- отметки о присутствии в жидкости посторонних веществ, примесей крови, прочих включений;
- определение концентрации аминокислот, солей и др.
Изменение цвета и запаха – вероятный признак нарушений в работе мочевыделительной системы. При камнях может повреждаться слизистая почек и мочевыделительных путей, поэтому признаком камнеобразования часто становится помутнение урины и следы крови в ней. Белок, повышенное количество лейкоцитов и пенистость указывает на развитие воспалительного процесса, который сопровождает образование конкрементов.
На патологический процесс в почках также указывает отклонение от норм плотности и кислотности мочи. При камнях в урине находят осадок песка и солей, которые образуют те самые конкременты. Биохимический анализ также выявляет отклонения: увеличение концентрации аминокислот и солей.
При необходимости врач назначает повторные или дополнительные исследования. Они могут понадобиться для диагностики заболевания и чтобы определить характер камнеобразования.
Среди урологических патологий лидирующее место занимает мочекаменная болезнь, которой в одинаковой степени подвержены мужчины и женщины. Диагностика данного заболевания и подтверждение диагноза проводится на основании симптоматики и результатов лабораторных исследований.
Мочекаменная болезнь может проявиться в любой возрастной группе, чаще происходит нарушение работы мочевыделительной системы в возрасте от 25 до 50 лет. В отдельных регионах данная патология чаще встречается у мужчин и сопровождается сопутствующими заболеваниями.
Мочекаменной болезни подвержены люди любого возраста и пола. Диагностируется при помощи медицинских клинических анализов и общих жалоб пациента. Для заболевания характерно образование камней в мочевыделительной системе. Они могут быть разными по величине и диаметру, чаще всего встречается песок. Бывают и образования размерами от 0,5 см до 5—6 см.
По специфическому запаху, измененному цвету мочи и периодическим ноющим болям в спине, можно с большей вероятностью диагностировать мочекаменное заболевание, хотя это и требует дополнительных анализов.
Признаки мочекаменной болезни в анализе мочи
Уролитиаз – патология обмена веществ, характеризуется образованием конкрементов в любом участке мочевыводящих путей. Заболеванию в равной мере подвержены представители обоих полов старше 30 лет. При подозрении на мочекаменную болезнь, анализ мочи является первым звеном диагностики. Результат исследования дает представление о химическом составе образований, наличии вторичного воспалительного процесса.
Человек может годами носить в почке камни и даже не подозревать этого. Клинические проявления возникают при начале движения конкремента и при перекрытии им мочевыводящих протоков. Основной симптом – сильнейшая боль – почечная колика, изменяется количество мочеиспусканий и качества урины. Какие жалобы предъявляют пациенты:
- Дизурический синдром. При обструкции конкрементами возникают трудности с выведением жидкости, суточное количество мочеиспусканий уменьшается. Движение камней в нижней части мочеточника, напротив, вызывает частое непреодолимое желание помочиться.
- Изменяется внешний вид урины. Чаще всего пугает появление крови, моча приобретает розовый цвет из-за того, что острые шипы камней травмируют слизистую. Другая жалоба – обнаружение мутного осадка. Хлопья в моче могут быть заметны невооруженным взглядом. Такое состояние сопровождается тупой болью в пояснице или внизу живота, субфебрильной температурой.
Spot Cleaner — это специальный аппарат для вакуумной чистки кожи лица в домашних условиях. Видя, такую популярность этого средства мы решили предложить его и вашему вниманию.
- Изменение кислотности. В норме pH урины нейтральна – 7,0. При окислении (показателях выше 7,0) возникает подозрение на образование уратов. Ощелачивание способствует развитию фосфатов, в их пользу говорят и обнаруженные крупные хлопья в моче. Слабокислая среда показательна для оксалатов.
- Микрогематурия – показатели эритроцитов, превышающие 1 – 3 в п/зр., различается только под микроскопом. Макрогематурия заметна невооруженным глазом.
- Белок в моче появляется при сочетании мочекаменной патологии с воспалительным процессом.
- Повышенное содержание солей время от времени встречается у каждого человека, связано это с дефицитом потребления жидкости. Регулярный солевой осадок свидетельствует о развитии патологии. Обнаружение кристаллов струвитных камней говорит об инфекционной природе МКБ. Часто в дополнение определяют бактериурию и протеинурию.
Застой урины и травмирование слизистой способствуют развитию инфекционного процесса, поэтому проводится определение бактериологического титра и чувствительности к антимикробным препаратам.
Исследование урины – начальный этап диагностики при заболеваниях и патологиях мочевыводящей системы. Часто определить проблему удается по анализу мочи при мочекаменной болезни бессимптомного течения, на начальной стадии заболевания. Лечение и прогноз в таких случаях более благоприятный.
Редкие виды конкрементов
Помимо описанных выше камней в почках могут присутствовать и другие образования – цистиновые, белковые, холестериновые и прочие конкременты. Как вы понимаете, они также отличаются составом и некоторыми особенностями.
Так, струвиты представляют собой коралловидные конкременты, включающие в состав магний, карбонат кальция и фосфат аммония. Они быстро растут, окрашены в белый цвет, который может иметь желтоватый оттенок.
Очень редко в организме образуются холестериновые конкременты. Они черные, мягкие и легко крошащиеся. Мягкой консистенцией обладают и округлые цистиновые камни, окрашенные в желтовато-белые цвета, отличающиеся гладкостью поверхности. На фоне генетического дефекта, под воздействием которого образуется дефицит ксантиноксидазы, формируются ксантиновые конкременты.
Белковые камни обычно формируются из фибрина, к которому примешиваются соли с бактериями. Их отличают небольшие размеры, мягкая консистенция, плоская форма. Цвет таких конкрементов – белый. В образовании карбонатных камней принимают участие кальциевые соли угольной кислоты. Такие конкременты окрашены в белый цвет, имеют гладкую поверхность, демонстрируют разнообразные формы и мягкую консистенцию.